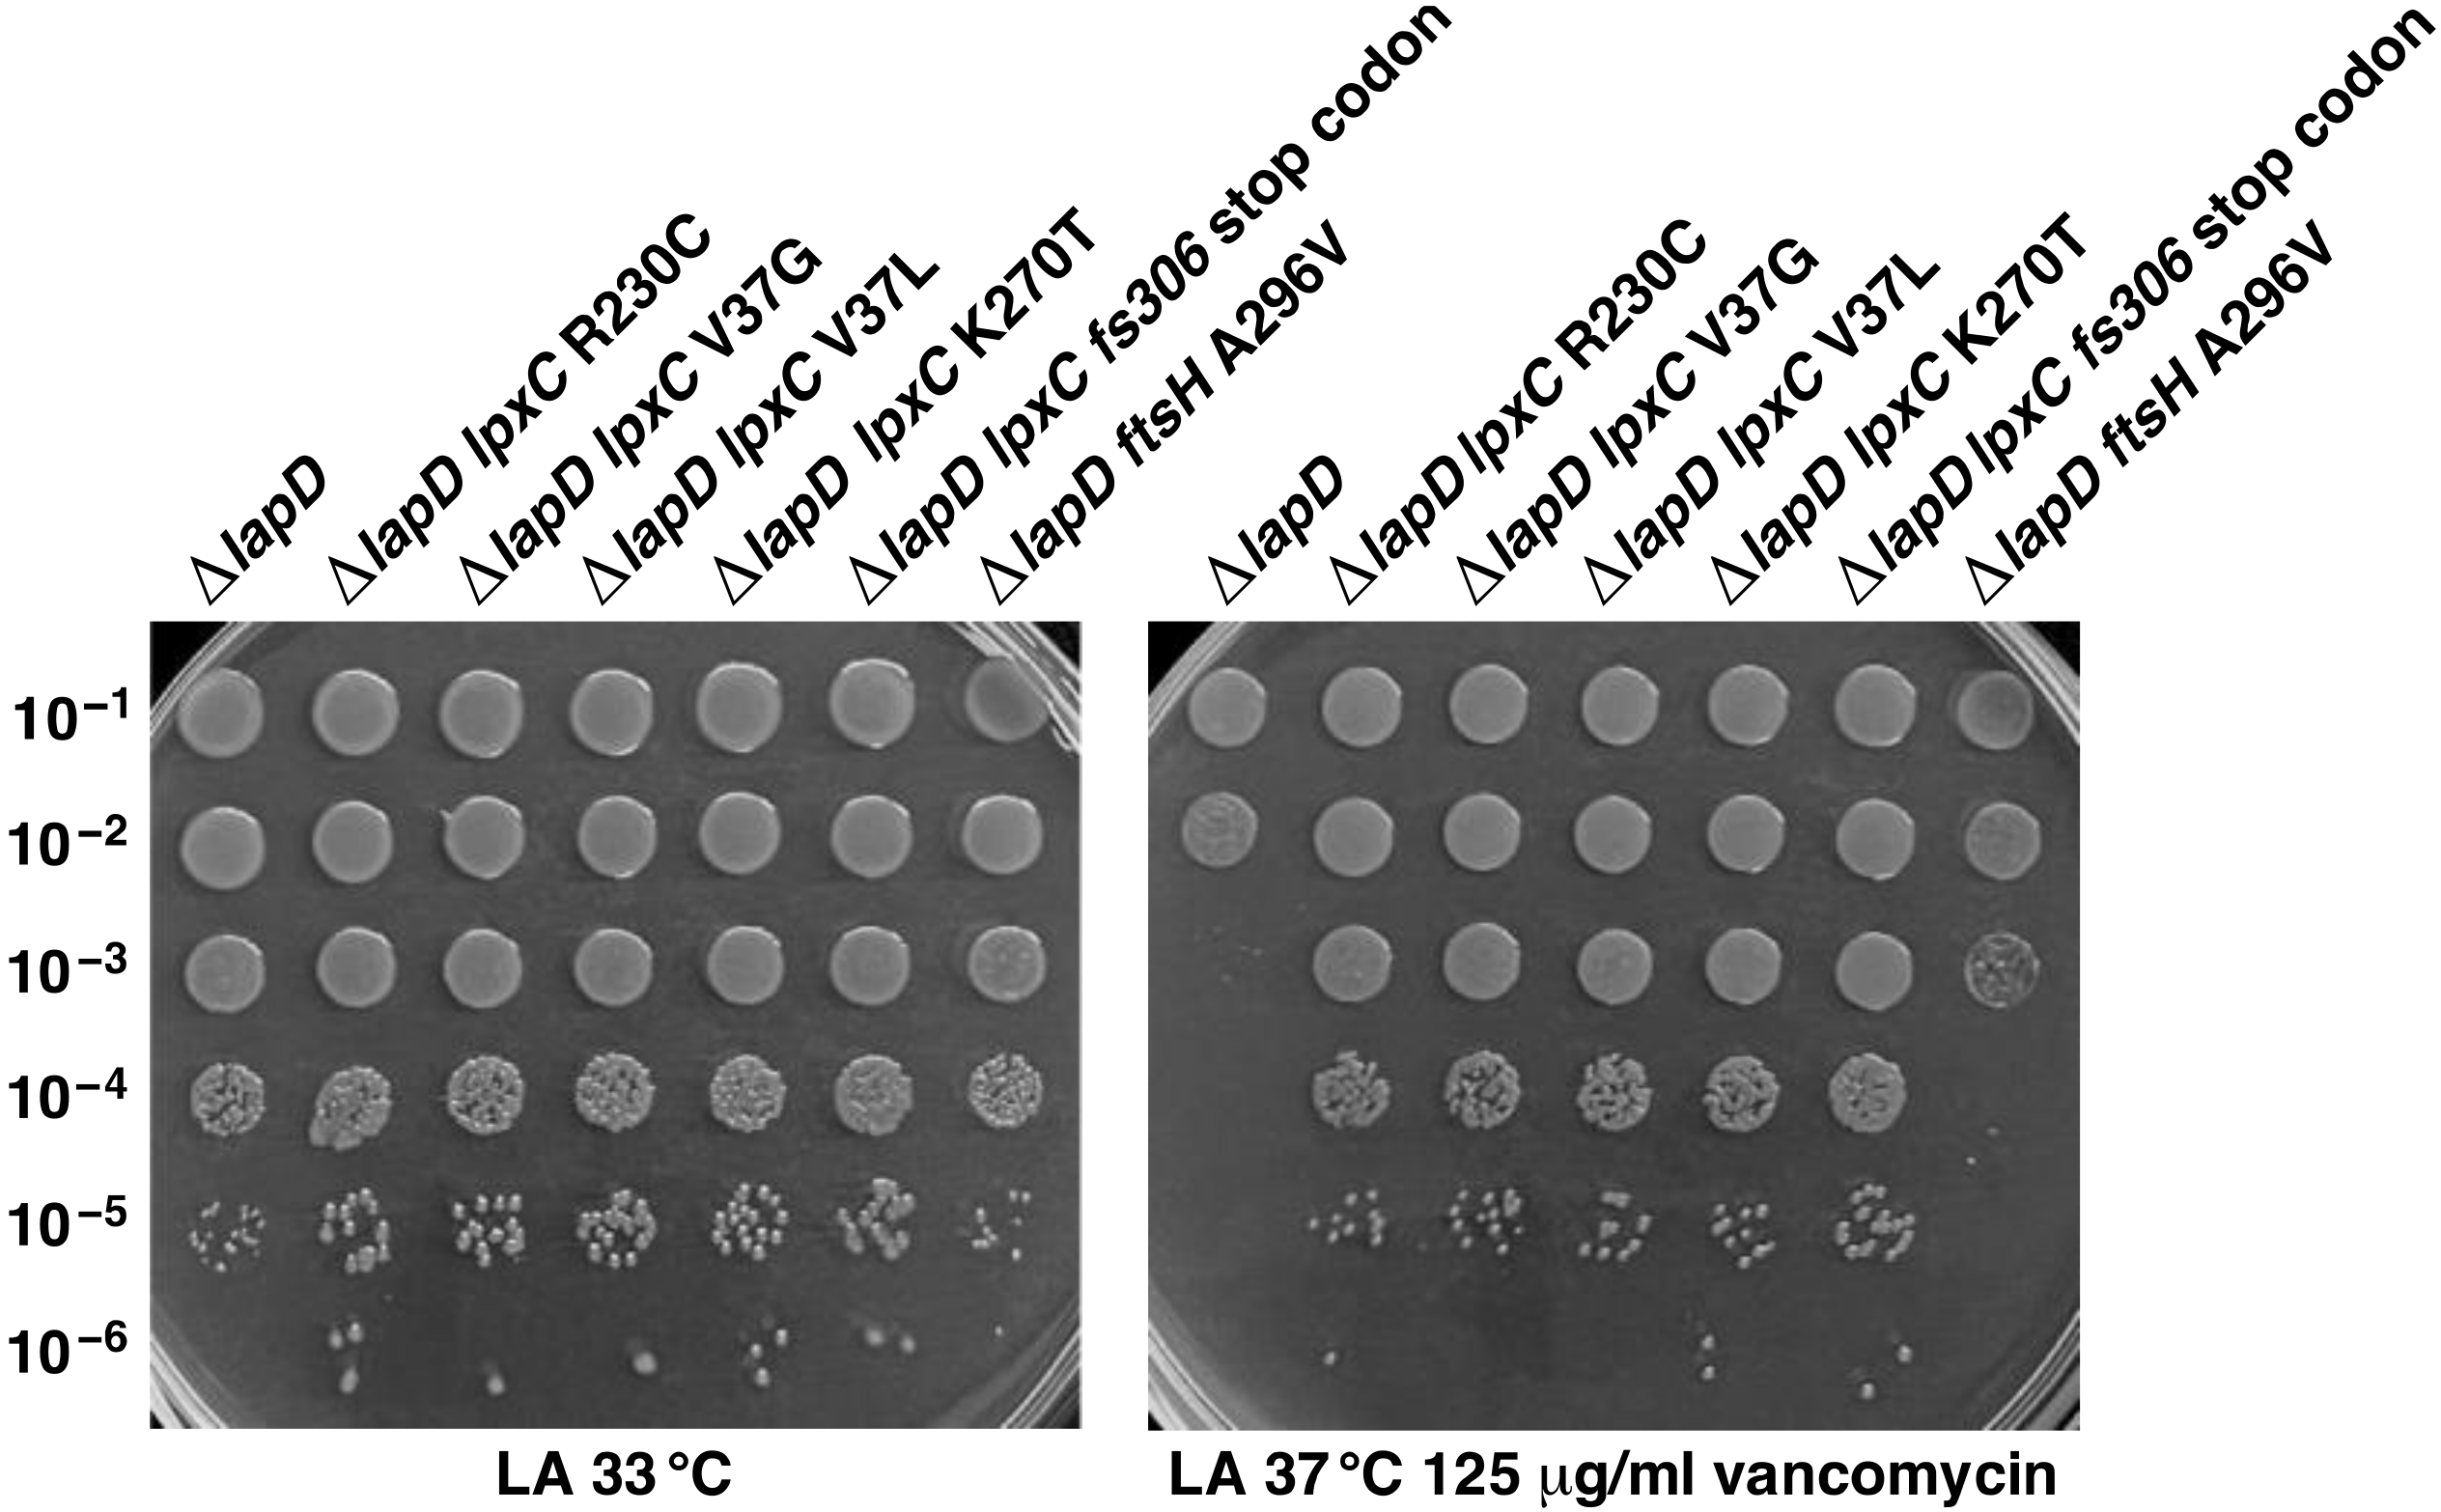
Ijms 23 09706 g006
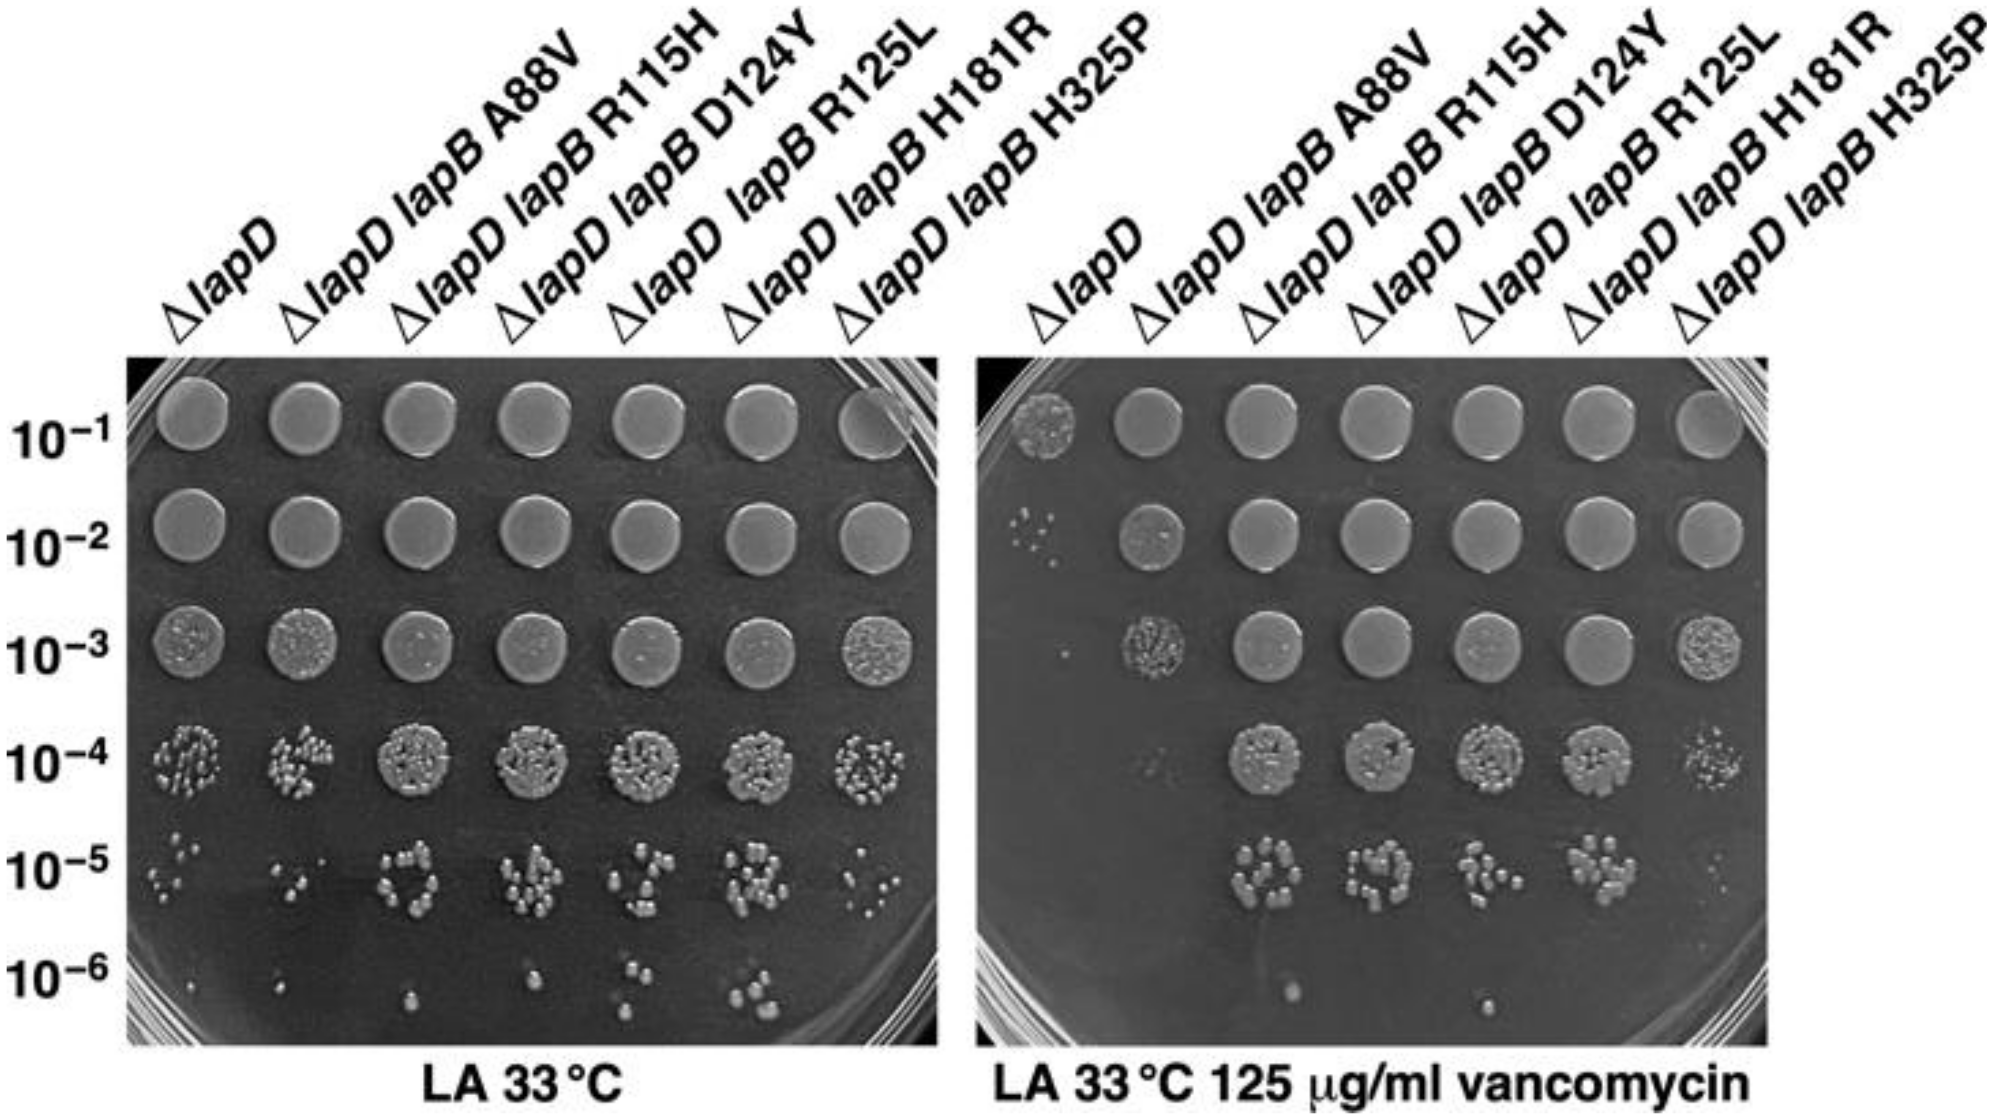
Ijms 23 09706 g007
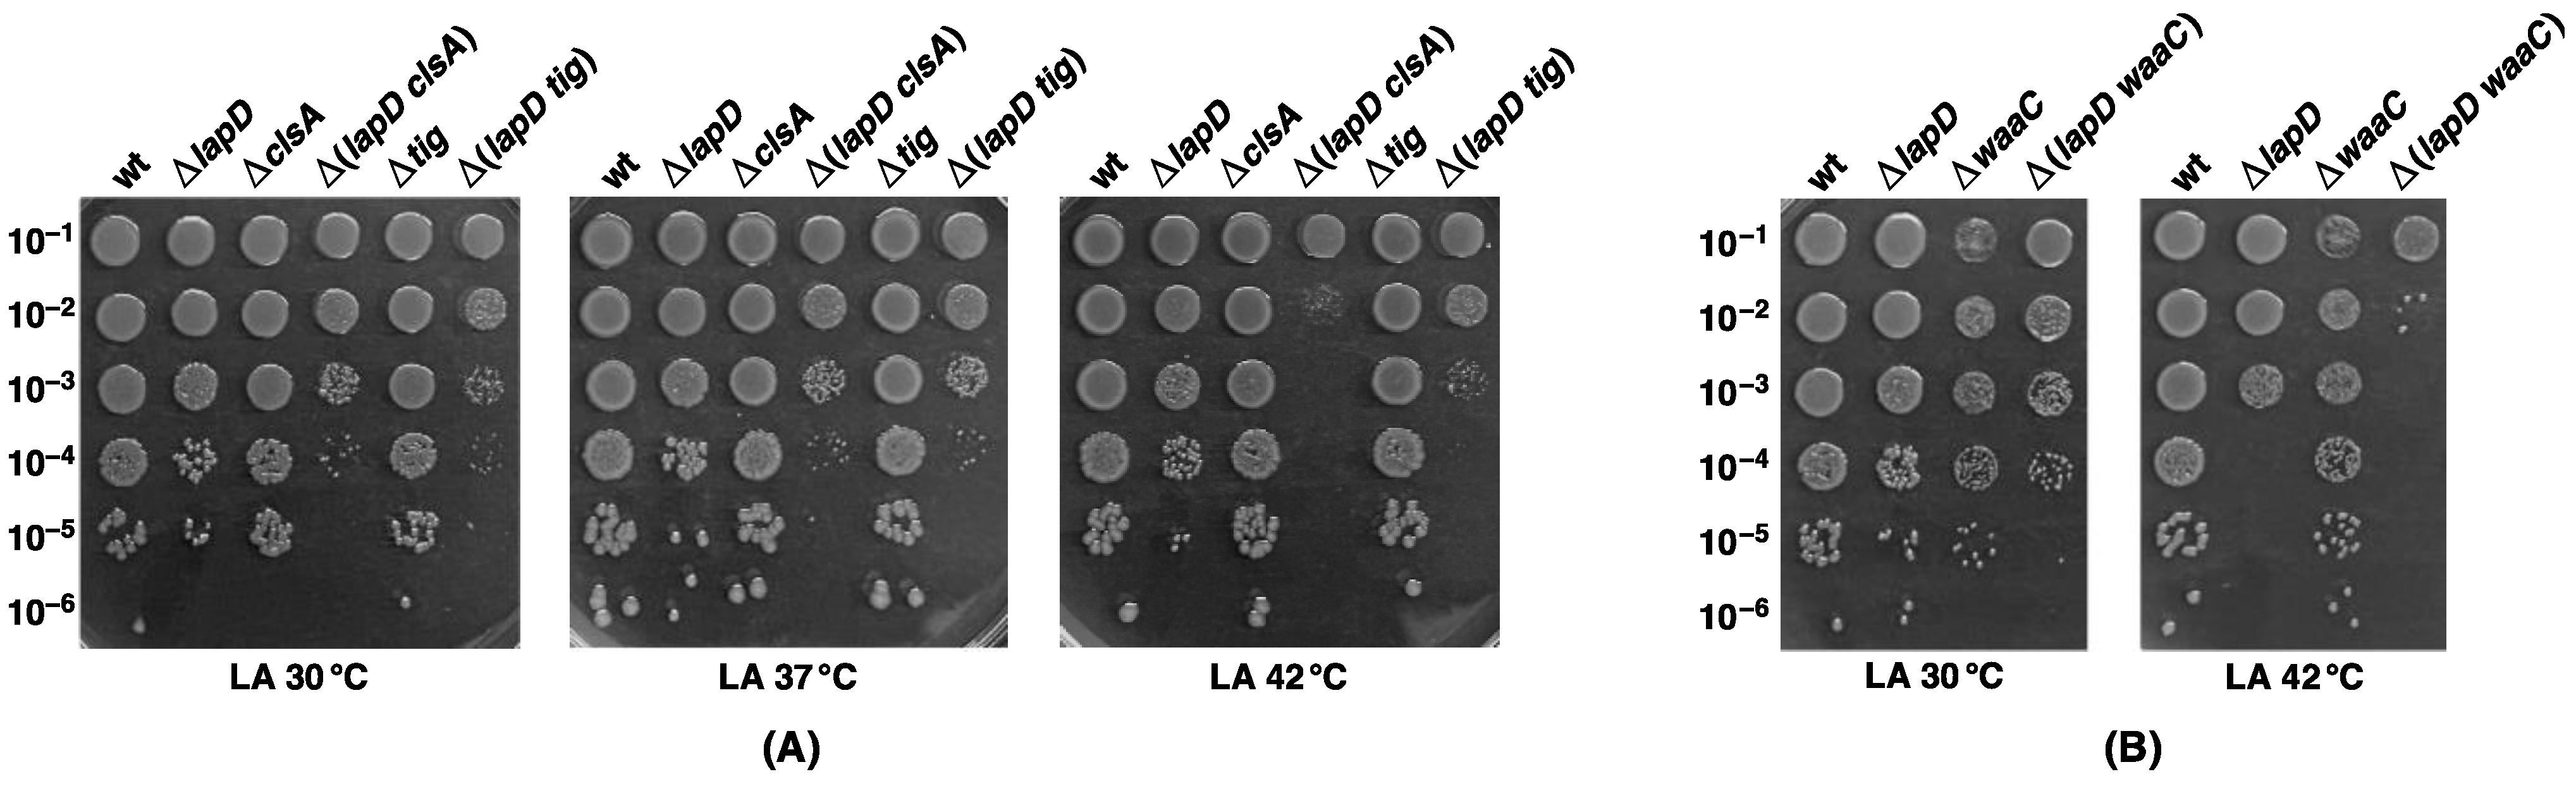
Ijms 23 09706 g008

A New Factor LapD Is Required for the Regulation of LpxC Amounts and Lipopolysaccharide Trafficking
Abstract
:1. Introduction
2. Results
2.1. LapD Is Part of LapA/LapB Complex and Co-Purifies with Several Proteins Involved in LPS and Phospholipid Biosynthesis
2.2. LapD Is Required to Maintain Levels of LpxC
2.3. Suppressor Mutations That Stabilize LpxC Can Restore the Wild-Type-like Growth of ΔlapD Bacteria on Vancomycin-Supplemented Growth Medium
2.4. Suppressor Mutations in the lapB Gene That Prevent LpxC Degradation and Restore the Growth of lapC190 Mutant Bacteria Can Also Restore the Wild-Type-like Growth of ΔlapD Bacteria on Vancomycin-Supplemented Growth Medium
2.5. Reduction in the LPS Synthesis Is Lethal for ΔlapD Bacteria
2.6. LapD Is Essential When Either LpxL or LpxM Late Acyl Transferase Is Absent and the Conditional Lethality When Cardiolipin Synthase A or WaaC Heptosyl Transferase Is Absent
2.7. Single Amino Acid Suppressor Mutations in the msbA Gene Can Bypass the Lethality of Δ(lpxL lapD) and Δ(lpxM lapD) Bacteria
2.8. Absence of LapD Leads to Retention of LPS in the Inner Membrane
2.9. Absence of LapD Causes the Constitutive Induction of LPS Defects Inducible RpoE-Dependent Stress Response
2.10. The RpoE-Regulated MicA sRNA Is Required for the Viability of ΔlapD Bacteria
2.11. Multicopy Suppressor Analysis to Identify Factors That Could Be Limiting When LapD Is Absent
2.12. Impact on LpxC Levels upon Overexpression of Genes That Overcome the Ts Phenotype of ΔlapD Bacteria
2.13. SrrA Does Not Regulate Transcription of the lpxC Gene
2.14. Catalytic Activity of AcpP Is Required for Its Multicopy Suppression of Growth Defects of ΔlapD Bacteria
2.15. LapD Is Required for Bacteria That Lack Six Major Cytoplasmic Peptidyl-Prolyl Cis/Trans Isomerases, Which Is Due to a Specific Requirement for Trigger Factor
3. Discussion
4. Materials and Methods
4.1. Bacterial Strains, Plasmids and Media
4.2. Purification of LapD and LapB
4.3. Immunoblotting to Estimate Amounts of LpxC
4.4. Identification of Multicopy Suppressors Whose Overexpression Suppresses Temperature and Vancomycin Sensitivity of ΔlapD Bacteria
4.5. Introduction of Various Suppressor Mutations Mapping to lpxC, lapB, ftsH and msbA in ΔlapD and Its Derivatives
4.6. Isolation of Suppressor Mutations That Confer Viability to Δ(lpxL lapD) and Δ(lpxM lapD) Derivatives and Their Mapping
4.7. RNA Purification and q-RT-PCR Analysis
4.8. Separation of Inner and Outer Membranes to Quantify LPS
4.9. Growth Analysis and Measurement of β-galactosidase Activity
Author Contributions
Funding
Institutional Review Board Statement
Informed Consent Statement
Data Availability Statement
Acknowledgments
Conflicts of Interest
References
- Nikaido, H. Molecular Basis of Bacterial Outer Membrane Permeability Revisited. Microbiol. Mol. Biol. Rev. 2003, 67, 593–656. [Google Scholar] [CrossRef] [PubMed]
- Klein, G.; Wieczorek, A.; Szuster, M.; Raina, S. Checkpoints That Regulate Balanced Biosynthesis of Lipopolysaccharide and Its Essentiality in Escherichia coli. Int. J. Mol. Sci. 2021, 23, 189. [Google Scholar] [CrossRef] [PubMed]
- Raetz, C.R.H.; Whitfield, C. Lipopolysaccharide endotoxins. Annu. Rev. Biochem. 2002, 71, 635–700. [Google Scholar] [CrossRef] [PubMed]
- Raetz, C.R.; Reynolds, C.M.; Trent, M.S.; Bishop, R.E. Lipid A Modification Systems in Gram-Negative Bacteria. Annu. Rev. Biochem. 2007, 76, 295–329. [Google Scholar] [CrossRef]
- Galloway, S.M.; Raetz, C.R. A mutant of Escherichia coli defective in the first step of endotoxin biosynthesis. J. Biol. Chem. 1990, 265, 6394–6402. [Google Scholar] [CrossRef]
- Anderson, M.; Bull, H.; Galloway, S.; Kelly, T.; Mohan, S.; Radika, K.; Raetz, C. UDP-N-acetylglucosamine acyltransferase of Escherichia coli. The first step of endotoxin biosynthesis is thermodynamically unfavorable. J. Biol. Chem. 1993, 268, 19858–19865. [Google Scholar] [CrossRef]
- Mohan, S.; Kelly, T.M.; Eveland, S.S.; Raetz, C.R.; Anderson, M.S. An Escherichia coli gene (FabZ) encoding (3R)-hydroxymyristoyl acyl carrier protein dehydrase. Relation to fabA and suppression of mutations in lipid A biosynthesis. J. Biol. Chem. 1994, 269, 32896–32903. [Google Scholar] [CrossRef]
- Anderson, M.S.; Bulawa, C.E.; Raetz, C.R.H. The biosynthesis of gram-negative endotoxin. Formation of lipid A precursors from UDP-GlcNAc in extracts of Escherichia coli. J. Biol. Chem. 1985, 260, 15536–15541. [Google Scholar] [CrossRef]
- Klein, G.; Lindner, B.; Brabetz, W.; Brade, H.; Raina, S. Escherichia coli K-12 suppressor-free mutants lacking early glycosyltransferases and late acetyltransferases: Minimal lipopolysaccharide structure and induction of envelope stress response. J. Biol. Chem. 2009, 284, 15369–15389. [Google Scholar] [CrossRef]
- Vorachek-Warren, M.K.; Ramirez, S.; Cotter, R.J.; Raetz, C.R.H. A Triple Mutant of Escherichia coli Lacking Secondary Acyl Chains on Lipid A. J. Biol. Chem. 2002, 277, 14194–14205. [Google Scholar] [CrossRef] [Green Version]
- Klein, G.; Lindner, B.; Brade, H.; Raina, S. Molecular basis of lipopolysaccharide heterogeneity in Escherichia coli: Envelope stress-responsive regulators control the incorporation of glycoforms with a third 3-deoxy-α-d-manno-oct-2-ulosonic acid and rhamnose. J. Biol. Chem. 2011, 286, 42787–42807. [Google Scholar] [CrossRef]
- Klein, G.; Müller-Loennies, S.; Lindner, B.; Kobylak, N.; Brade, H.; Raina, S. Molecular and structural basis of inner core lipopolysaccharide alterations in Escherichia coli: Incorporation of glucuronic acid and phosphoethanolamine in the heptose region. J. Biol. Chem. 2013, 288, 8111–8127. [Google Scholar] [CrossRef]
- Moon, K.; Gottesman, S. A PhoQ/P-regulated small RNA regulates sensitivity of Escherichia coli to antimicrobial peptides. Mol. Microbiol. 2009, 74, 1314–1330. [Google Scholar] [CrossRef]
- Klein, G.; Raina, S. Regulated Control of the Assembly and Diversity of LPS by Noncoding sRNAs. BioMed. Res. Int. 2015, 2015, 153561. [Google Scholar] [CrossRef]
- Ogura, T.; Inoue, K.; Tatsuta, T.; Suzaki, T.; Karata, K.; Young, K.; Su, L.-H.; Fierke, C.A.; Jackman, J.; Raetz, C.R.H.; et al. Balanced biosynthesis of major membrane components through regulated degradation of the committed enzyme of lipid A biosynthesis by the AAA protease FtsH (HflB) in Escherichia coli. Mol. Microbiol. 1999, 31, 833–844. [Google Scholar] [CrossRef]
- Sorensen, P.G.; Lutkenhaus, J.; Young, K.; Eveland, S.S.; Anderson, M.S.; Raetz, C.R. Regulation of UDP-3-O-[R-3-hydroxymyristoyl]-N-acetylglucosamine Deacetylase in Escherichia coli: The second enzymatic step of lipid a biosynthesis. J. Biol. Chem. 1996, 271, 25898–25905. [Google Scholar] [CrossRef]
- Klein, G.; Kobylak, N.; Lindner, B.; Stupak, A.; Raina, S. Assembly of Lipopolysaccharide in Escherichia coli Requires the Essential LapB Heat Shock Protein. J. Biol. Chem. 2014, 289, 14829–14853. [Google Scholar] [CrossRef]
- Thomanek, N.; Arends, J.; Lindemann, C.; Barkovits, K.; Meyer, H.E.; Marcus, K.; Narberhaus, F. Intricate Crosstalk between Lipopolysaccharide, Phospholipid and Fatty Acid Metabolism in Escherichia coli Modulates Proteolysis of LpxC. Front. Microbiol. 2019, 9, 3285. [Google Scholar] [CrossRef]
- Emiola, A.; Andrews, S.S.; Heller, C.; George, J. Crosstalk between the lipopolysaccharide and phospholipid pathways during outer membrane biogenesis in Escherichia coli. Proc. Natl. Acad. Sci. USA 2016, 113, 3108–3113. [Google Scholar] [CrossRef]
- Mahalakshmi, S.; Sunayana, M.R.; SaiSree, L.; Reddy, M. yciM is an essential gene required for regulation of lipopolysaccharide synthesis in Escherichia coli. Mol. Microbiol. 2014, 91, 145–157. [Google Scholar] [CrossRef]
- Biernacka, D.; Gorzelak, P.; Klein, G.; Raina, S. Regulation of the First Committed Step in Lipopolysaccharide Biosynthesis Catalyzed by LpxC Requires the Essential Protein LapC (YejM) and HslVU Protease. Int. J. Mol. Sci. 2020, 21, 9088. [Google Scholar] [CrossRef]
- Clairfeuille, T.; Buchholz, K.R.; Li, Q.; Verschueren, E.; Liu, P.; Sangaraju, D.; Park, S.; Noland, C.L.; Storek, K.M.; Nickerson, N.N.; et al. Structure of the essential inner membrane lipopolysaccharide-PbgA complex. Nature 2020, 584, 479–483. [Google Scholar] [CrossRef]
- Guest, R.L.; Guerra, D.S.; Wissler, M.; Grimm, J.; Silhavy, T.J. YejM Modulates Activity of the YciM/FtsH Protease Complex to Prevent Lethal Accumulation of Lipopolysaccharide. mBio 2020, 11, e00598-20. [Google Scholar] [CrossRef]
- Fivenson, E.M.; Bernhardt, T.G. An Essential Membrane Protein Modulates the Proteolysis of LpxC to Control Lipopolysaccharide Synthesis in Escherichia coli. mBio 2020, 11, e00939-20. [Google Scholar] [CrossRef]
- Nguyen, D.; Kelly, K.; Qiu, N.; Misra, R. YejM Controls LpxC Levels by Regulating Protease Activity of the FtsH/YciM Complex of Escherichia coli. J. Bacteriol. 2020, 202, e00303–e00320. [Google Scholar] [CrossRef]
- Cian, M.B.; Giordano, N.P.; Masilamani, R.; Minor, K.E.; Dalebroux, Z.D. Salmonella enterica serovar Typhimurium uses PdgA/YejM to regulate lipopolysaccharide assembly during bacteremia. Infect. Immun. 2020, 88, e00758-19. [Google Scholar]
- Doerrler, W.T.; Gibbons, H.S.; Raetz, C.R.H. MsbA-dependent translocation of lipids across the inner membrane of Escherichia coli. J. Biol. Chem. 2004, 279, 45102–45109. [Google Scholar] [CrossRef]
- Sperandeo, P.; Lau, F.K.; Carpentieri, A.; De Castro, C.; Molinaro, A.; Dehò, G.; Silhavy, T.J.; Polissi, A. Functional Analysis of the Protein Machinery Required for Transport of Lipopolysaccharide to the Outer Membrane of Escherichia coli. J. Bacteriol. 2008, 190, 4460–4469. [Google Scholar] [CrossRef]
- Mi, W.; Li, Y.; Yoon, S.H.; Ernst, R.K.; Walz, T.; Liao, M. Structural basis of MsbA-mediated lipopolysaccharide transport. Nature 2017, 549, 233–237. [Google Scholar] [CrossRef]
- Ho, H.; Miu, A.; Alexander, M.K.; Garcia, N.K.; Oh, A.; Zilberleyb, I.; Reichelt, M.; Austin, C.D.; Tam, C.; Shriver, S.; et al. Structural basis for dual-mode inhibition of the ABC transporter MsbA. Nature 2018, 557, 196–201. [Google Scholar] [CrossRef] [PubMed]
- Padayatti, P.S.; Lee, S.C.; Stanfield, R.L.; Wen, P.-C.; Tajkhorshid, E.; Wilson, I.A.; Zhang, Q. Structural Insights into the Lipid A Transport Pathway in MsbA. Structure 2019, 27, 1114–1123. [Google Scholar] [CrossRef] [PubMed]
- Gorzelak, P.; Klein, G.; Raina, S. Molecular basis of essentiality of early critical steps in the lipopolysaccharide biogenesis in Escherichia coli K-12: Requirement of MsbA, cardiolipin, LpxL, LpxM and GcvB. Int. J. Mol. Sci. 2021, 22, 5099. [Google Scholar] [CrossRef] [PubMed]
- Douglass, M.V.; Cléon, F.; Trent, M.S. Cardiolipin aids in lipopolysaccharide transport to the gram-negative outer membrane. Proc. Natl. Acad. Sci. USA 2021, 118, e2018329118. [Google Scholar] [CrossRef]
- Murata, M.; Fujimoto, H.; Nishimura, K.; Charoensuk, K.; Nagamitsu, H.; Raina, S.; Kosaka, T.; Oshima, T.; Ogasawara, N.; Yamada, M. Molecular strategy for survival at a critical high temperature in Escherichia coli. PLoS ONE 2011, 6, e20063. [Google Scholar] [CrossRef]
- Li, G.; Hamamoto, K.; Kitakawa, M. Inner Membrane Protein YhcB Interacts with RodZ Involved in Cell Shape Maintenance in Escherichia coli. ISRN Mol. Biol. 2012, 2012, 304021. [Google Scholar] [CrossRef]
- Goodall, E.C.A.; Isom, G.L.; Rooke, J.L.; Pullela, K.; Icke, C.; Yang, Z.; Boelter, G.; Jones, A.; Warner, I.; Da Costa, R.; et al. Loss of YhcB results in dysregulation of coordinated peptidoglycan, LPS and phospholipid synthesis during Escherichia coli cell growth. PLoS Genet. 2021, 17, e1009586. [Google Scholar] [CrossRef]
- Mehla, J.; Liechti, G.; Morgenstein, R.M.; Caufield, J.H.; Hosseinnia, A.; Gagarinova, A.; Phanse, S.; Goodacre, N.; Brockett, M.; Sakhawalkar, N.; et al. ZapG (YhcB/DUF1043), a novel cell division protein in gamma-proteobacteria linking the Z-ring to septal peptidoglycan synthesis. J. Biol. Chem. 2021, 296, 100700. [Google Scholar] [CrossRef]
- Sung, C.G.; Choi, U.; Lee, C.-R. Phenotypic characterization of a conserved inner membrane protein YhcB in Escherichia coli. J. Microbiol. 2020, 58, 598–605. [Google Scholar] [CrossRef]
- Byers, D.M.; Gong, H. Acyl carrier protein: Structure–function relationships in a conserved multifunctional protein family. Biochem. Cell Biol. 2007, 85, 649–662. [Google Scholar] [CrossRef]
- Wojtkiewicz, P.; Biernacka, D.; Gorzelak, P.; Stupak, A.; Klein, G.; Raina, S. Multicopy Suppressor Analysis of Strains Lacking Cytoplasmic Peptidyl-Prolyl cis/trans Isomerases Identifies Three New PPIase Activities in Escherichia coli That Includes the DksA Transcription Factor. Int. J. Mol. Sci. 2020, 21, 5843. [Google Scholar] [CrossRef]
- Clementz, T.; Zhou, Z.; Raetz, C.R.H. Function of the Escherichia coli msbB gene, a multicopy suppressor of htrB knockouts, in the acylation of lipid A. Acylation by MsbB follows laurate incorporation by HtrB. J. Biol. Chem. 1997, 272, 10353–10360. [Google Scholar] [CrossRef] [Green Version]
- Raetz, C.R.; Larson, T.J.; Dowhan, W. Gene cloning for the isolation of enzymes of membrane lipid synthesis: Phosphatidylserine synthase overproduction in Escherichia coli. Proc. Natl. Acad. Sci. USA 1977, 74, 1412–1416. [Google Scholar] [CrossRef]
- Karow, M.; Raina, S.; Georgopoulos, C.; Fayet, O. Complex phenotypes of null mutations in the htr genes, whose products are essential for Escherichia coli growth at elevated temperatures. Res. Microbiol. 1991, 142, 289–294. [Google Scholar] [CrossRef]
- Tan, B.K.; Bogdanov, M.; Zhao, J.; Dowhan, W.; Raetz, C.R.H.; Guan, Z. Discovery of a cardiolipin synthesis utilizing phosphadylethanolamine and phosphadylglycerol as substrates. Proc. Natl. Acad. Sci. USA 2012, 109, 16504–16509. [Google Scholar] [CrossRef]
- Hiraoka, S.; Matsuzaki, H.; Shibuya, I. Active increase in cardiolipin synthesis in the stationary growth phase and its physiological significance in Escherichia coli. FEBS Lett. 1993, 336, 221–224. [Google Scholar] [CrossRef]
- Dartigalongue, C.; Missiakas, D.; Raina, S. Characterization of the Escherichia coli σE regulon. J. Biol. Chem. 2001, 276, 20866–20875. [Google Scholar] [CrossRef]
- Dartigalongue, C.; Loferer, H.; Raina, S. EcfE, a new essential inner membrane protease: Its role in the regulation of heat shock response in Escherichia coli. EMBO J. 2001, 20, 5908–5918. [Google Scholar] [CrossRef]
- A Rhodius, V.; Suh, W.C.; Nonaka, G.; West, J.; A Gross, C. Conserved and Variable Functions of the σE Stress Response in Related Genomes. PLoS Biol. 2005, 4, e2. [Google Scholar] [CrossRef] [PubMed]
- Klein, G.; Stupak, A.; Biernacka, D.; Wojtkiewicz, P.; Lindner, B.; Raina, S. Multiple Transcriptional Factors Regulate Transcription of the rpoE Gene in Escherichia coli under Different Growth Conditions and When the Lipopolysaccharide Biosynthesis Is Defective. J. Biol. Chem. 2016, 291, 22999–23019. [Google Scholar] [CrossRef] [PubMed]
- Gogol, E.B.; Rhodius, V.A.; Papenfort, K.; Vogel, J.; Gross, C.A. Small RNAs endow a transcriptional activator with essential repressor functions for single-tier control of a global stress regulon. Proc. Natl. Acad. Sci. USA 2011, 108, 12875–12880. [Google Scholar] [CrossRef] [PubMed]
- Kitagawa, M.; Ara, T.; Arifuzzaman, M.; Ioka-Nakamichi, T.; Inamoto, E.; Toyonaga, H.; Mori, H. Complete set of ORF clones of Escherichia coli ASKA library (A Complete Set of E. coli K-12 ORF Archive): Unique Resources for Biological Research. DNA Res. 2005, 12, 291–299. [Google Scholar] [CrossRef] [Green Version]
- Wall, E.; Majdalani, N.; Gottesman, S. The Complex Rcs Regulatory Cascade. Annu. Rev. Microbiol. 2018, 72, 111–139. [Google Scholar] [CrossRef]
- Konovalova, A.; Mitchell, A.M.; Silhavy, T.J. A lipoprotein/β-barrel complex monitors lipopolysaccharide integrity transducing information across the outer membrane. eLife 2016, 5, e15276. [Google Scholar] [CrossRef]
- Zhu, L.; Cronan, J.E. The Conserved Modular Elements of the Acyl Carrier Proteins of Lipid Synthesis Are Only Partially Interchangeable. J. Biol. Chem. 2015, 290, 13791–13799. [Google Scholar] [CrossRef]
- Gully, D.; Bouveret, E. A protein network for phospholipid synthesis uncovered by a variant of the tandem affinity purification method in Escherichia coli. Proteomics 2006, 6, 282–293. [Google Scholar] [CrossRef]
- Cronan, J.E. The chain-flipping mechanism of ACP (acyl carrier protein)-dependent enzymes appears universal. Biochem. J. 2014, 460, 157–163. [Google Scholar] [CrossRef]
- Klein, G.; Wojtkiewicz, P.; Biernacka, D.; Stupak, A.; Gorzelak, P.; Raina, S. Identification of Substrates of Cytoplasmic Peptidyl-Prolyl Cis/Trans Isomerases and Their Collective Essentiality in Escherichia coli. Int. J. Mol. Sci. 2020, 21, 4212. [Google Scholar] [CrossRef]
- Fuhrer, F.; Langklotz, S.; Narberhaus, F. The C-terminal end of LpxC is required for degradation by the FtsH protease. Mol. Microbiol. 2006, 59, 1025–1036. [Google Scholar] [CrossRef]
- Moon, K.; Six, D.; Lee, H.-J.; Raetz, C.R.H.; Gottesman, S. Complex transcriptional and post-transcriptional regulation of an enzyme for lipopolysaccharide modification. Mol. Microbiol. 2013, 89, 52–64. [Google Scholar] [CrossRef]
- Papenfort, K.; Pfeiffer, V.; Mika, F.; Lucchini, S.; Hinton, J.C.D.; Vogel, J. σE-dependent small RNAs of Salmonella respond to membrane stress by accelerating global omp mRNA decay. Mol. Microbiol. 2006, 62, 1674–1688. [Google Scholar] [CrossRef]
- Reynolds, C.M.; Kalb, S.R.; Cotter, R.J.; Raetz, C.R.H. A Phosphoethanolamine Transferase Specific for the Outer 3-Deoxy-D-manno-octulosonic Acid Residue of Escherichia coli Lipopolysaccharide: Identification of the eptb gene and ca2+ hypersensitivity of an eptb deletion mutant. J. Biol. Chem. 2005, 280, 21202–21211. [Google Scholar] [CrossRef] [Green Version]
- Oh, E.; Becker, A.H.; Sandikci, A.; Huber, D.; Chaba, R.; Gloge, F.; Nichols, R.J.; Typas, A.; Gross, C.A.; Kramer, G.; et al. Selective Ribosome Profiling Reveals the Cotranslational Chaperone Action of Trigger Factor In Vivo. Cell 2011, 147, 1295–1308. [Google Scholar] [CrossRef]
- A Teter, S.; A Houry, W.; Ang, D.; Tradler, T.; Rockabrand, D.; Fischer, G.; Blum, P.; Georgopoulos, C.; Hartl, F. Polypeptide Flux through Bacterial Hsp70: DnaK Cooperates with Trigger Factor in Chaperoning Nascent Chains. Cell 1999, 97, 755–765. [Google Scholar] [CrossRef]
- Deuerling, E.; Schulze-Specking, A.; Tomoyasu, T.; Mogk, A.; Bukau, B. Trigger factor and DnaK cooperate in folding of newly synthesized proteins. Nature 1999, 400, 693–696. [Google Scholar] [CrossRef]
- Kang, P.J.; A Craig, E. Identification and characterization of a new Escherichia coli gene that is a dosage-dependent suppressor of a dnaK deletion mutation. J. Bacteriol. 1990, 172, 2055–2064. [Google Scholar] [CrossRef]
- Fricke, J.; Neuhard, J.; A Kelln, R.; Pedersen, S. The cmk gene encoding cytidine monophosphate kinase is located in the rpsA operon and is required for normal replication rate in Escherichia coli. J. Bacteriol. 1995, 177, 517–523. [Google Scholar] [CrossRef]
- Yamanaka, K.; Ogura, T.; Koonin, E.V.; Niki, H.; Hiraga, S. Multicopy suppresors, mssA and mssB, of an smbA mutation of Escherichia coli. Mol. Gen. Genet. 1994, 243, 9–16. [Google Scholar] [CrossRef]
- Rock, C.; Jackowski, S. Regulation of phospholipid synthesis in Escherichia coli. Composition of the acyl-acyl carrier protein pool in vivo. J. Biol. Chem. 1982, 257, 10759–10765. [Google Scholar] [CrossRef]
- De Lay, N.R.; Cronan, J.E. In Vivo Functional Analyses of the Type II Acyl Carrier Proteins of Fatty Acid Biosynthesis. J. Biol. Chem. 2007, 282, 20319–20328. [Google Scholar] [CrossRef]
- Prince, J.P.; Bolla, J.R.; Fisher, G.L.M.; Mäkelä, J.; Fournier, M.; Robinson, C.V.; Arciszewska, L.K.; Sherratt, D.J. Acyl carrier protein promotes MukBEF action in Escherichia coli chromosome organization-segregation. Nat. Commun. 2021, 12, 6721. [Google Scholar] [CrossRef]
- Butland, G.; Alvarez, J.; Li, J.; Yang, W.; Yang, X.; Canadien, V.; Starostine, A.; Richards, D.; Beattie, B.; Krogan, N.; et al. Interaction network containing conserved and essential protein complexes in Escherichia coli. Nature 2005, 433, 531–537. [Google Scholar] [CrossRef] [PubMed]
- Niba, E.T.E.; Naka, Y.; Nagase, M.; Mori, H.; Kitakawa, M. A Genome-wide Approach to Identify the Genes Involved in Biofilm Formation in E. coli. DNA Res. 2007, 14, 237–246. [Google Scholar] [CrossRef] [PubMed]
- Choi, J.S.; Kim, W.; Suk, S.; Park, H.; Bak, G.; Yoon, J.; Lee, Y. The small RNA, SdsR, acts as a novel type of toxin in Escherichia coli. RNA Biol. 2018, 15, 1319–1335. [Google Scholar] [CrossRef] [PubMed]
- Prince, C.; Jia, Z. An Unexpected Duo: Rubredoxin Binds Nine TPR Motifs to Form LapB, an Essential Regulator of Lipopolysaccharide Synthesis. Structure 2015, 23, 1500–1506. [Google Scholar] [CrossRef]
- Datsenko, K.A.; Wanner, B.L. One-step inactivation of chromosomal genes in Escherichia coli K-12 using PCR products. Proc. Natl. Acad. Sci. USA 2000, 97, 6640–6645. [Google Scholar] [CrossRef]
- Baird, L.; Lipinska, B.; Raina, S.; Georgopoulos, C. Identification of the Escherichia coli sohB gene, a multicopy suppressor of the HtrA (DegP) null phenotype. J. Bacteriol. 1991, 173, 5763–5770. [Google Scholar] [CrossRef]
- Raina, S.; Missiakas, D.; Baird, L.; Kumar, S.; Georgopoulos, C. Identification and transcriptional analysis of the Escherichia coli htrE operon which is homologous to pap and related pilin operons. J. Bacteriol. 1993, 175, 5009–5021. [Google Scholar] [CrossRef] [Green Version]

| Genotype | Number of Transductants | Viability in ΔlapD | |
|---|---|---|---|
| P1 ΔlapD LA 30 °C | P1 ΔlapB M9 30 °C | ||
| wt | 953 | 96 small colonies | viable |
| lpxA2(ts) | 12 sc 1 | 650 | not viable |
| lpxB1(ts) | 9 | 439 | not viable |
| lapC190 | 17 sc | 475 | not viable |
| Genotype | P1 ΔlapD Number of Transductants LA 30 °C | Viability and Colony Size |
|---|---|---|
| wt | 1243 | viable |
| ΔlpxM | 6 | not viable |
| ΔlpxL | 13 | not viable |
| Δ(lpxM lapD) msbA S120L | 620 | viable small size |
| Δ(lpxM lapD) msbA M160I | 786 | viable medium size |
| Δ(lpxM lapD) msbA I177M | 730 | viable small size |
| Δ(lpxM lapD) msbA Y287A | 1490 | viable normal size |
| Δ(lpxM lapD) msbA D431Y | 735 | viable normal size |
| Δ(lpxM lapD) msbA S165C | 1130 | viable normal size |
| Δ(lpxM lapD) msbA D498Y | 1267 | viable normal size |
| ΔwaaC | 433 | viable small size not viable at 42 °C |
| ΔclsA | 378 | viable small size not viable at 42 °C |
| Name | Number of Transformants | Function | |
|---|---|---|---|
| LA 44 °C | vancomycin | ||
| vector alone | 9 small colonies | 6 small colonies | |
| acpP | 750 | ND 1 | acyl carrier protein |
| dksA | 486 | ND | transcriptional regulator |
| srrA | 520 | ND | transcriptional regulator |
| yfgM | 430 | ND | inner membrane protein, substrate of FtsH |
| accB | 511 | ND | acetylocoenzyme carboxylase |
| rcsF | ND | 701 medium size colonies | colanic acid regulator |
| artJ | 473 | ND | L-arginine ABC transporter |
| Name | P1 ΔlapD Number of Transductants LA 33 °C | Features |
|---|---|---|
| wt | 1300 | viable |
| Δ6ppi | 5 | not viable |
| ΔppiB | 9 | not viable |
| ΔppiB + plpxH+ | 920 | viable |
| ΔppiC | 1430 | viable |
| Δtig | 230 sc 1 | conditional lethality at high temperatures |
| ΔfklB | 490 sc | viable but smaller colony size |
| ΔfkpB | 735 | viable |
| ΔslyD | 506 | viable but colony size reduced above 42 °C |
| Strains | Genotype | Reference |
| BW25113 | lacIqrrnBT14 ΔlacZWJ16 hsdR514 ΔaraBADAH33 ΔrhaBADLD78 | [75] |
| SR23678 | BW25113 lapD<>aph | This study |
| SR23743 | BW25113 lapD<>frt | This study |
| SR17532 | BW25113 φ(rpoEP3-lacZ) | [9] |
| SR23686 | SR17532 lapD<>aph | This study |
| SR8233 | W3110 waaC<>cat | [9] |
| SR23691 | SR23678 waaC<>cat | This study |
| SR23320 | BW25113 clsA<>frt | This study |
| SR23769 | SR23320 lapD<>aph | This study |
| SR8522 | W3110 micA<>cat | [11] |
| SR23852 | BW25113 micA<>cat | This study |
| SR23900 | SR23678 micA<>cat | This study |
| SR21068 | BW25113 tig<>cat | [57] |
| SR23773 | SR21068 lapD<>aph | This study |
| SR23684 | Δ(lpxL lapD) msbA L412P | This study |
| SR23685 | Δ(lpxM lapD) msbA V287A | This study |
| SR23699 | BW25113 lpxM msbA S120L | This study |
| SR23701 | BW25113 lpxM msbA I177M | This study |
| SR23703 | BW25113 lpxM msbA M160I | This study |
| SR23705 | BW25113 lpxM msbA D431Y | This study |
| SR23707 | BW25113 lpxM msbA V287A | This study |
| SR23709 | BW25113 lpxM msbA S164C | This study |
| SR23711 | BW25113 lpxM msbA D498Y | This study |
| GK6075 | BW25113 lapC190 | [21] |
| GK6078 | lapC190 lpxC K270T | [21] |
| GK6094 | lapC190 lpxC fs306 stop codon | [21] |
| SR22727 | lapC190 lpxC R230C | [21] |
| SR22731 | lapC190 lpxC V37G | [21] |
| SR22738 | lapC190 lpxC V37L | [21] |
| GK6095 | lapC190 ftsH A296V | [21] |
| SR22724 | lapC190 lapB H325P | [21] |
| SR22726 | lapC190 lapB A88V | [21] |
| SR22730 | lapC190 lapB H181R | [21] |
| SR22733 | lapC190 lapB R115H | [21] |
| GK6084 | lapC190 lapB D124Y | [21] |
| GK6087 | lapC190 lapB R125L | [21] |
| SR23812 | lpxC R230C | This study |
| SR23814 | lpxC V37G | This study |
| SR23816 | lpxC V37L | This study |
| SR23818 | lpxC K270T | This study |
| SR23820 | lpxC fs306 stop codon | This study |
| SR23822 | ftsH A296V | This study |
| SR23836 | lpxC R230C lapD<>aph | This study |
| SR23838 | lpxC V37G lapD<>aph | This study |
| SR23840 | lpxC V37L lapD<>aph | This study |
| SR23842 | lpxC K270T lapD<>aph | This study |
| SR23844 | lpxC fs306 stop codon lapD<>aph | This study |
| SR23905 | SR23840 micA<>cat | This study |
| SR23907 | SR23842 micA<>cat | This study |
| SR23909 | SR23844 micA<>cat | This study |
| SR23911 | SR23838 micA<>cat | This study |
| SR23846 | ftsH A296V lapD<>aph | This study |
| SR23857 | lapB H325P lapD<>aph | This study |
| SR23859 | lapB A88V lapD<>aph | This study |
| SR23861 | lapB H181R lapD<>aph | This study |
| SR23863 | lapB R115H lapD<>aph | This study |
| SR23865 | lapB D124Y lapD<>aph | This study |
| SR23867 | lapB R125L lapD<>aph | This study |
| SR22995 | SR20491 Δ(lapA lapB) | This study |
| SR23138 | BW25113 oppA<>ada | This study |
| SM101 | lpxA2(ts) | CGSC, Yale |
| MN7 | lpxB1(ts) | CGSC, Yale |
| SR23798 | SR23678 + pCA24N | This study |
| SR23790 | SR23678 + pacpP+ | This study |
| SR23784 | SR23678 + pyfgM+ | This study |
| SR23786 | SR23678 + pdksA+ | This study |
| SR23792 | SR23678 + psrrA+ | This study |
| SR23796 | SR23678 + paccD+ | This study |
| SR23794 | SR23678 + pymgG+ | This study |
| SR23788 | SR23678 + partJ+ | This study |
| SR23729 | SR23678 + pEB540 pBAD-CBP-ACP | This study |
| SR23732 | SR23678 + pEB547 pBAD-CBP-ACP (S36C) | This study |
| SR23735 | SR23678 + pEB797 pBAD-CBP-ACP (S36T) | This study |
| SR23738 | SR23678 + pBAD24 | This study |
| Plasmids | Genotype | Reference |
| pCA24N | IPTG-inducible expression vector cmR | [51] |
| pDUET | expression vector | Our collection |
| pKD3 | oriR6Kg, bla(AmpR), kan, rgnB(Ter), cat | [75] |
| pKD13 | oriR6Kg, bla(AmpR), kan, rgnB(Ter) | [75] |
| pKD46 | araBp-gam-bet-exo, bla(AmpR), repA101(ts) | [75] |
| pCP20 | ts replicon with inducible FLP recombinase | [75] |
| JW5539 | lapD+ in pCA24N | [51] |
| pSR23599 | lapD+ in pDUET | This study |
| pSR23790 | acpP+ in pCA24N | This study |
| pEB540 | pBAD-CBP-ACP | [55] |
| pEB547 | pBAD-CBP-ACP (S36C) | [55] |
| pEB797 | pBAD-CBP-ACP (S36T) | [55] |
Publisher’s Note: MDPI stays neutral with regard to jurisdictional claims in published maps and institutional affiliations. |
© 2022 by the authors. Licensee MDPI, Basel, Switzerland. This article is an open access article distributed under the terms and conditions of the Creative Commons Attribution (CC BY) license (https://creativecommons.org/licenses/by/4.0/).
Share and Cite
Wieczorek, A.; Sendobra, A.; Maniyeri, A.; Sugalska, M.; Klein, G.; Raina, S. A New Factor LapD Is Required for the Regulation of LpxC Amounts and Lipopolysaccharide Trafficking. Int. J. Mol. Sci. 2022, 23, 9706. https://doi.org/10.3390/ijms23179706
Wieczorek A, Sendobra A, Maniyeri A, Sugalska M, Klein G, Raina S. A New Factor LapD Is Required for the Regulation of LpxC Amounts and Lipopolysaccharide Trafficking. International Journal of Molecular Sciences. 2022; 23(17):9706. https://doi.org/10.3390/ijms23179706
Chicago/Turabian StyleWieczorek, Alicja, Anna Sendobra, Akshey Maniyeri, Magdalena Sugalska, Gracjana Klein, and Satish Raina. 2022. "A New Factor LapD Is Required for the Regulation of LpxC Amounts and Lipopolysaccharide Trafficking" International Journal of Molecular Sciences 23, no. 17: 9706. https://doi.org/10.3390/ijms23179706
APA StyleWieczorek, A., Sendobra, A., Maniyeri, A., Sugalska, M., Klein, G., & Raina, S. (2022). A New Factor LapD Is Required for the Regulation of LpxC Amounts and Lipopolysaccharide Trafficking. International Journal of Molecular Sciences, 23(17), 9706. https://doi.org/10.3390/ijms23179706

